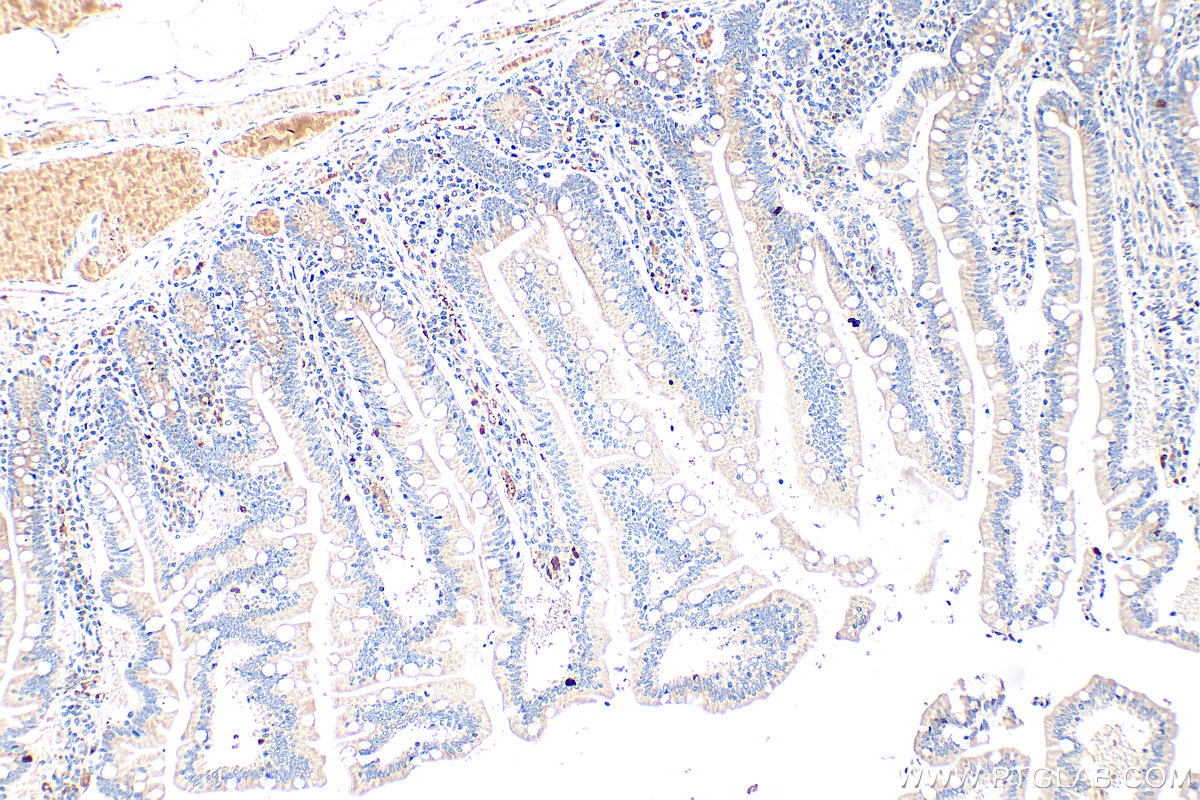
Immunohistochemistry (IHC) staining of human small intestine tissue using peptide YY Polyclonal antibody (24294-1-AP)

Tested Applications
| Positive IHC detected in | human small intestine tissue, human colon tissue, human pancreas tissue Note: suggested antigen retrieval with TE buffer pH 9.0; (*) Alternatively, antigen retrieval may be performed with citrate buffer pH 6.0 |
Recommended dilution
| Application | Dilution |
|---|---|
| Immunohistochemistry (IHC) | IHC : 1:200-1:800 |
| It is recommended that this reagent should be titrated in each testing system to obtain optimal results. | |
| Sample-dependent, Check data in validation data gallery. | |
Published Applications
| WB | See 2 publications below |
| IHC | See 1 publications below |
| IF | See 2 publications below |
Product Information
24294-1-AP targets peptide YY in WB, IHC, IF, ELISA applications and shows reactivity with human samples.
| Tested Reactivity | human |
| Cited Reactivity | human, mouse |
| Host / Isotype | Rabbit / IgG |
| Class | Polyclonal |
| Type | Antibody |
| Immunogen |
CatNo: Ag17939 Product name: Recombinant human PYY protein Source: e coli.-derived, PGEX-4T Tag: GST Domain: 29-97 aa of BC041057 Sequence: YPIKPEAPGEDASPEELNRYYASLRHYLNLVTRQRYGKRDGPDRLLSKTFFPDGEDRPVRSRSEGPDLW Predict reactive species |
| Full Name | peptide YY |
| Calculated Molecular Weight | 97 aa, 11 kDa |
| GenBank Accession Number | BC041057 |
| Gene Symbol | Peptide YY |
| Gene ID (NCBI) | 5697 |
| RRID | AB_2879477 |
| Conjugate | Unconjugated |
| Form | Liquid |
| Purification Method | Antigen affinity purification |
| UNIPROT ID | P10082 |
| Storage Buffer | PBS with 0.02% sodium azide and 50% glycerol, pH 7.3. |
| Storage Conditions | Store at -20°C. Stable for one year after shipment. Aliquoting is unnecessary for -20oC storage. 20ul sizes contain 0.1% BSA. |
Background Information
Peptide YY (PYY) is a short (36-amino acid) peptide hormone that is released from endocrine cells in the gut. Its name is derived from the presence of two tyrosine (Y) amino acids at both ends of the molecule.
Protocols
| Product Specific Protocols | |
|---|---|
| IHC protocol for peptide YY antibody 24294-1-AP | Download protocol |
| Standard Protocols | |
|---|---|
| Click here to view our Standard Protocols |
Publications
| Species | Application | Title |
|---|---|---|
Anal Chem Development of a Primary Human Intestinal Epithelium Enriched in L-Cells for Assay of GLP-1 Secretion. | ||
Front Cell Infect Microbiol Appetite Suppression and Interleukin 17 Receptor Signaling Activation of Colonic Mycobiota Dysbiosis Induced by High Temperature and High Humidity Conditions. | ||
Am J Cancer Res PYY modulates the tumorigenesis and progression of colorectal cancer unveiled by proteomics |